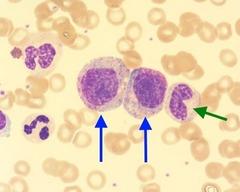
Question Image

Hemo exam 2 digital test
Quiz by Wayne Aguiar
Feel free to use or edit a copy
includes Teacher and Student dashboards
Measure skillsfrom any curriculum
Measure skills
from any curriculum
Tag the questions with any skills you have. Your dashboard will track each student's mastery of each skill.
With a free account, teachers can
- edit the questions
- save a copy for later
- start a class game
- automatically assign follow-up activities based on students’ scores
- assign as homework
- share a link with colleagues
- print as a bubble sheet
30 questions
Show answers
- Q1See imageMyelocyte (blue ARROW)30s
- Q2See imageSickle cell30s
- Q3See imageMetamyelocyte30s
- Q4See imageBand neutrophil30s
- Q5See imageHypersegmented neutrophil30s
- Q6See imagePelger Huet30s
- Q7See imageBasophil30s
- Q8See imageEosinophil30s
- Q9See imageDohle body30s
- Q10See imageToxic granulation30s
- Q11See imageAuer rod30s
- Q12See imageMonocyte30s
- Q13See imageLymphocyte (mature)30s
- Q14See imageLymphocyte (reactive,activated)30s
- Q15See imageHairy lymphocytic cells30s